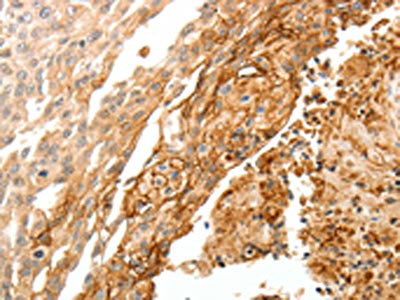

TGM1 Antibody
-
中文名稱:TGM1兔多克隆抗體
-
貨號:CSB-PA284640
-
規(guī)格:¥1100
-
圖片:
-
其他:
產(chǎn)品詳情
-
Uniprot No.:
-
基因名:TGM1
-
別名:ARCI1 antibody; Epidermal TGase antibody; ICR2 antibody; KTG antibody; LI antibody; LI1 antibody; Protein glutamine gamma glutamyltransferase K antibody; Protein-glutamine gamma-glutamyltransferase K antibody; TG(K) antibody; TGase 1 antibody; TGASE antibody; TGase K antibody; TGase-1 antibody; TGK antibody; TGM1 antibody; TGM1_HUMAN antibody; Transglutaminase 1 (K polypeptide epidermal type I; protein glutamine gamma glutamyltransferase) antibody; Transglutaminase 1 antibody; Transglutaminase K antibody; Transglutaminase; keratinocyte antibody; Transglutaminase-1 antibody
-
宿主:Rabbit
-
反應(yīng)種屬:Human
-
免疫原:Synthetic peptide of Human TGM1
-
免疫原種屬:Homo sapiens (Human)
-
標記方式:Non-conjugated
-
抗體亞型:IgG
-
純化方式:Antigen affinity purification
-
濃度:It differs from different batches. Please contact us to confirm it.
-
保存緩沖液:-20°C, pH7.4 PBS, 0.05% NaN3, 40% Glycerol
-
產(chǎn)品提供形式:Liquid
-
應(yīng)用范圍:ELISA,IHC
-
推薦稀釋比:
Application Recommended Dilution ELISA 1:2000-1:5000 IHC 1:25-1:100 -
Protocols:
-
儲存條件:Upon receipt, store at -20°C or -80°C. Avoid repeated freeze.
-
貨期:Basically, we can dispatch the products out in 1-3 working days after receiving your orders. Delivery time maybe differs from different purchasing way or location, please kindly consult your local distributors for specific delivery time.
-
用途:For Research Use Only. Not for use in diagnostic or therapeutic procedures.
相關(guān)產(chǎn)品
靶點詳情
-
功能:Catalyzes the cross-linking of proteins and the conjugation of polyamines to proteins. Responsible for cross-linking epidermal proteins during formation of the stratum corneum. Involved in cell proliferation.
-
基因功能參考文獻:
- p.Ile140Met, p.Pro184Ser, p.Gly357Asp mutations pathogenic PMID: 26990434
- We also reveal that TGM1 modulates lung epithelial junction protein expression, suggesting a potentially protective role for hypoxia-induced TGM1 in pulmonary disease. PMID: 27423780
- A novel TGM1 variant c.1085T>G was found in an Emirati family. The mutation causes a nonsynonymous protein change (p.Leu362Arg) that affects a highly conserved residue in the catalytic core domain of the calcium-dependent transglutaminase-1. PMID: 28236338
- that the up-regulation of molecular signatures for antimicrobial and innate defense responses is characteristic of skin with a transglutaminase 1 deficiency. PMID: 27442430
- Seven of 10 probands with a compound heterozygous TGM1 genotype had a mutation at either arginine 307 or 315, providing evidence that mutations at these sites are temperature sensitive and highlighting the importance of these residues in the pathogenesis of bathing suit ichthyosis PMID: 28403434
- The results strongly supported the participation of TGM1 in the regulation of gastric cancer development. The authors found evidence that the mechanism of action of TGM1 in regulating gastric cancer cell might involve the Wnt signaling pathway, as loss of TGM1 expression in gastric cancer cells led to a significant suppression of Wnt signaling activities. PMID: 27660242
- we identified three novel mutations and one reported mutation in the TGM1 and ABCA12 genes, respectively, in affected siblings of five Saudi unrelated families. PMID: 27061915
- As a further application of the substrate peptide, several substrate candidates of TG1 that may be essential for cornified envelope formation were identified and characterized. PMID: 27416753
- Data indicate a decrease in transglutaminases TG1 and TG3 transcripts by about 70% in foreskins from patients with balanitis xerotica obliterans (BXO) BXO in comparison with patients without BXO and an increase in transglutaminase TG2 mRNA levels by 2.9 fold. PMID: 27649154
- In summary, we have identified three novel sequence variants, one in TGM1 and two in ALOXE3, in three consanguineous families segregating lamellar ichthyosis and congenital ichthyosiform erythroderma types of autosomal recessive congenital ichthyosis. PMID: 26578203
- Our results thus indicated that the TGM1 mutation affects the formation of corni fi ed cell envelope by multiple mechanisms and leads to an almost identical clinical phenotype of generalized erythema and scales. PMID: 26220141
- Two siblings with autosomal recessive congenital ichthyosis, were found to carry a novel aetiological TGM1 mutation that leads to the synthesis of multiple abnormal transcripts. PMID: 25754682
- mRNA expression of transglutaminase 1 and transglutaminase 3 was significantly decreased in patients with chronic periodontitis compared with a healthy control group. PMID: 24112124
- In this study, we found that 14 different TGM1 mutations have been identified and reported in 13 individuals with ARCI from 8 families with congental ichthyosis, comprising 9 missense mutations, 1 deletion and 1 splice-site mutation . PMID: 25154629
- Structure-function implication on a novel homozygous Trp250/Gly mutation of transglutaminase-1 (TGM1) observed in a patient of autosomal recessive congenital ichthyosis is invoked from a bioinformatics analysis. PMID: 25180191
- IgA-anti-TG1 antibodies were found in 2% and IgA-anti-TG3 antibodies in 3% of patients with active atopic dermatitis (AD). Two out of the 5 patients with AD and concomitant celiac disease had IgA-anti-TG1 and IgA-anti-TG2 antibodies. PMID: 24885370
- All mutations, except a novel deletion of a single nucleotide in exon 13 (c.2149delC), have been reported previously in lamellar ichthyosis. PMID: 24261627
- Most of the mutations we identified in 20 israeli families with autosomal recessive congenital ichthyosis were located within the coding sequence of the TGM1 gene PMID: 23621129
- We add a Korean case of genetically identified autosomal recessive congenital icthyosis, confirmed by the presence of compound heterozygous mutations in the TGM1 gene. PMID: 24314425
- analysis of a case of mild lamellar ichthyosis with compound heterozygous TGM1 mutations including the novel missense mutation p.Leu693Phe [case report] PMID: 23895935
- Two known pathogenic TGM1 mutations were detected in three large consanguineous Omani families with lamellar ichthyosis PMID: 23689228
- Congenital lamellar ichthyosis in Tunisia is caused by a founder nonsense mutation in the TGM1 gene. PMID: 23192619
- TGM1 mutation spectra in Italian and Portuguese patients with autosomal recessive congenital ichthyosis. PMID: 23278109
- FATP4, ichthyin and TGM1 interact in lipid processing essential for maintaining the epidermal barrier function PMID: 23290633
- GGT may have a role in change in body mass index but not in waist cirumference PMID: 22972431
- TG1 and TG2 isoenzymes are highly active with the major activity attributed to TG1 in human saliva. PMID: 22080209
- Two transition/transversion (R37G, V112A), two nonsense mutations and two putative splice site of TGM1 are associated with lamellar ichthyosis. PMID: 23096117
- Genetic variation in the epidermal transglutaminase genes is not associated with atopic dermatitis. PMID: 23189155
- Autosomal recessive congenital ichthyosis patients with ALOX12B mutations and abnormal 12R-LOX expression, the colocalization signal for eLOX-3 and TGM1 was increased 4-fold. PMID: 22622417
- These findings confirm the hypothesis that only a restricted spectrum of TGM1 mutations leads to a bathing suit ichthyosis and/or a self-improving collodion ichthyosis phenotype. PMID: 22801880
- Two mutations of the TGM1 gene,c.2278C>T and c.1223_1227delACACA which are observed in high frequency in Galician patients with autosomal recessive congenital ichthyosis, were most likely founded in the Galician territory instead of being brought here by migrants. PMID: 22511925
- beta-actin is a target for the activity of recombinant human transglutaminase 1 in cultured chick telecephalon cell cultures. PMID: 21789544
- Our splicing assay, together with bioinformatic prediction tools, supports the pathological effect of the recently identified c.984+1G>A mutation in the TGM1 gene and unravels the molecular mechanism by which c.984+1G>A acts. PMID: 22435431
- TGM1 genotypes of the family were used to determine parental origins of the mutations. PMID: 22311480
- Transglutaminase in epidermis and neurological disease. PMID: 22220473
- We conclude that TG1-catalysed cross-linking, regulated by TIG3, might play an important role in the formation of neuronal tau inclusions in certain tauopathies PMID: 22009441
- TG1-catalyzed cross-linking and consequent polymerization of cytoskeletal and cytoskeleton-associated proteins may underlie corpora amylacea formation. PMID: 19464759
- Transglutaminase1 and its preferred substrate peptide K5 have a role in lamellar ichthyosis PMID: 20167857
- misfolding of TG1 mutants leads to ubiquitinylation and accumulation in the ER and aggresomes, and that abnormal intracellular processing of TG1 mutants may be an underlying cause of ichthyosis. PMID: 20663883
- four novel mutations in TGM1 gene result in decrease or absence of TGase activity in the skin and, as a consequence, cause the phenotype of autosomal recessive lamellar ichthyosis PMID: 19486042
- Mutations are closely related to previously described ones in bathing suit ichthyosis and self-healing collodion baby variants of lamellar ichthyosis and clustered in exons 5, 6 and 7 of TMG1 PMID: 19863506
- findings identify tissue transglutaminase as a key participant in an EGFR/Src-signaling pathway in breast-cancer cells and a potential target for inhibiting EGFR-promoted tumor progression. PMID: 20080707
- ALOX12B mutations are the leading cause of self-improving collodion ichthyosis in Scandinavia, followed by ALOXE3 mutations, and TGM1 mutations PMID: 19890349
- proposed that tTGase-mediated cross-linking is an another form of core histone modification and it may play a role of chromatin condensation during erythrocyte differentiation PMID: 12054678
- This enzyme is expressed in vivo in normal lung, preinvasive bronchial lesions, and lung cancer. PMID: 12654631
- transglutaminase 1 has a role in keratinocyte terminal differentiation after activation by TIG3 PMID: 12928434
- LEKTI deficiency in the epidermis and in hair roots at the protein level and an aberrant expression of other proteins, especially transglutaminase1 and 3, which may account for the impaired epidermal barrier in Netherton syndrome PMID: 15304086
- Treatment of human umbilical vein endothelial cells (HUVEC) with atorvastatin (1-10 microM) caused a clear increased expression of tTgase in both permeabilised and non-permeabilised HUVEC. PMID: 15313180
- analysis of transglutaminase 1 mutations in autosomal recessive congenital ichthyosis in Egyptian families PMID: 15665393
- In HEK 293T cell culture, transglutaminase 1 cross-links the N-terminal fragments of mutant huntingtin protein, therefore it could be involved in the cross-linking of huntingtin into intranuclear inclusions in Huntington disease. PMID: 15715085
顯示更多
收起更多
-
相關(guān)疾病:Ichthyosis, congenital, autosomal recessive 1 (ARCI1)
-
亞細胞定位:Membrane; Lipid-anchor.
-
蛋白家族:Transglutaminase superfamily, Transglutaminase family
-
數(shù)據(jù)庫鏈接:
Most popular with customers
-
Phospho-YAP1 (S127) Recombinant Monoclonal Antibody
Applications: ELISA, WB, IHC
Species Reactivity: Human
-
-
-
-
-
-
-
VDAC1 Recombinant Monoclonal Antibody
Applications: ELISA, WB, IHC
Species Reactivity: Human, Mouse, Rat